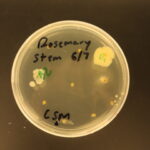

May 2020 Issue
Sleep Deprivation and a High Fat Diet During Adolescence Does Not Affect Hippocampal Structure in Adulthood
The negative effects of a high fat diet and sleep deprivation in adolescence on hippocampal volume and neurogenesis do not continue in adulthood.
Posted by John Lee on Wednesday, December 23rd, 2020 in May 2020, Adolescence, High Fat Diet, Hippocampal Volume, Neurogenesis, Sleep Deprivation
Investigating stress response to a social evaluative threat in female and male children with Autism Spectrum Disorder
An analysis of the cortisol stress responses to the Trier Social Stress Test and responses to social ability questionnaires in females and males with autism spectrum disorder.
Posted by John Lee on Wednesday, December 23rd, 2020 in May 2020,
Development of an Educational Platform for Teaching Young Students Complex Networking Topics using the Parallax BadgeWX
A platform was created that allows students to more thoroughly engage in group learning using models that teach complex networking concepts.
Posted by John Lee on Wednesday, December 23rd, 2020 in May 2020, Learning, Modeling, Parallax, Technology
The Optimization of a Commercial-Sized Hybrid Barrel-Panel Solar Oven for Implementation in Tropical Climates
The usability and temperature capabilities of a commercial-sized, easily replicable solar oven were improved upon through structural changes, temperature testing, and material comparisons, and cook trials were performed to understand functionality.
Posted by John Lee on Wednesday, December 23rd, 2020 in May 2020, solar oven, sustainable cooking, tropics
The Creation of a Passive Portable Solar Still: Utilizing Membrane Distillation
Investigating Desalination Possibilities in Membrane Disillation
Posted by John Lee on Wednesday, December 23rd, 2020 in May 2020, Desalination, electrospinning, Membrane Distillation, Solar Desalination, Sustainability
Analyzing the role of endothelial cell derived Jedi-1 in postnatal neurogenesis
Neural stem cells experience a decrease in quiescence in the absence of Jedi-1 positive endothelial cells.
Posted by John Lee on Wednesday, December 23rd, 2020 in May 2020, Endothelial cells, Jedi-1, neural stem cells, Neurogenesis
Feasibility assessment of heat transfer as an independent variable to compare cold exposure studies of brown adipose tissue
A flow-temperature sensing device was incorporated into a water-blanket system to calculate heat transfer for use as an independent varia-ble in cooling studies
Posted by John Lee on Wednesday, December 23rd, 2020 in May 2020, brown adipose tissue, cold exposure, thermoregulatory physiology
Maintenance and expansion of myeloid progenitor cells in 3D culture
This study aimed to find a better treatment of Myelodysplastic Syndrome using myeloid progenitor cells grown in 3D culture.
Posted by John Lee on Wednesday, December 23rd, 2020 in May 2020, 3D Culture, Myelodysplastic Syndrome, myeloid cells
Isolating Endophytes to Derive Novel Antibiotics
This paper describes the isolation of endophytes with bacterial resistance so that a novel antibiotic may be synthesized.
Posted by John Lee on Wednesday, December 23rd, 2020 in May 2020, Antibiotics, Endophytes, Medicinal Plants, Resistance
Investigating the Metabolic Characteristics of Brain Microvascular Endothelial Cells
Determining the metabolism of brain microvascular endothelial cells through conditional media testing.
Posted by John Lee on Wednesday, December 23rd, 2020 in May 2020, Blood Brain Barrier, Brain Microvascular Endothelial Cells, metabolism, Neurovascular Disease
Development of “Parkinson’s-like” disease in C. elegans Using Dextrose and a 6-OHDA Neurotoxin
Dextrose increased the neurotoxicity of the neurotoxin, 6-OHDA, in C. elegans in testing the development of “Parkinson’s-like” disease.
Posted by John Lee on Wednesday, December 23rd, 2020 in May 2020, C. elegans, Dextrose, Neurotoxin, Parkinson’s disease
Validating a Dual-Threshold Peak Detection for Calcium Signals Around Laser-Induced Epithelial Wounds
A comparison between an automated method of collection calcium peaks to a manual version to determine the accuracy of the automated system and gain insight into the role of calcium during the wound healing process.
Posted by John Lee on Wednesday, December 23rd, 2020 in May 2020, Calcium Signals, Peaks Detection
Tracking river movement and delta formation by analyzing sediment from the Brahmaputra river
The average grain size of Brahmaputra sediment samples from the Pleistocene and Holocene were compared to understand delta formation.
Posted by John Lee on Wednesday, December 23rd, 2020 in May 2020, Delta Formation, river migration, sediment distribution
Developing remote procedure calls for NetsBlox to facilitate climate change lessons in K-12 STEM education
Climate change services were implemented into NetsBlox, as linking computer science to outside fields of science is an effective method of teaching programming.
Posted by John Lee on Wednesday, December 23rd, 2020 in May 2020, block-based programming, climate change, Computer science education, K-12 education, STEM education
Development of a Python-based Platform for Teaching Computer Science
This project consists of the creation of a robotics platform built on Python and a curriculum for middle and high school students in order to increase the amount of students interested in computer science.
Posted by John Lee on Wednesday, December 23rd, 2020 in May 2020, Computer Science, education, python, Roboscape, Robotics
Analyzing the Spatial Organization of Tuberous Sclerosis Complex Tumor Cells Using Immunostaining and Computational Approaches
Immunostaining and Computational approaches through the HistoCAT software determined a non-random organization of cells in Subependymal Giant-Cell Astrocytomas (SEGAs), a type of Tuberous Sclerosis Complex tumor.
Posted by John Lee on Wednesday, December 23rd, 2020 in May 2020, HistoCAT, Pax6., Tuberous Sclerosis Complex
Analyzing the Effects of IFN-γ-Induced Repolarization on Bone Marrow Derived Macrophage Viability
Macrophage exposure to IFN- γ was tested to understand any viability decrease before application in upcoming experimentation.
Posted by John Lee on Wednesday, December 23rd, 2020 in May 2020, IFN-γ, Immunology, M1 macrophages, M2 macrophages, Macrophages, Repolarization, Viability
Provenance of Zircon in McMurdo Sound Antarctica
This study analyzes the ages of zircon minerals found in the ANDRILL core in order to track past ice flow.
Posted by John Lee on Wednesday, December 23rd, 2020 in May 2020, ANDRILL, Isotope, Provenance, Zircon